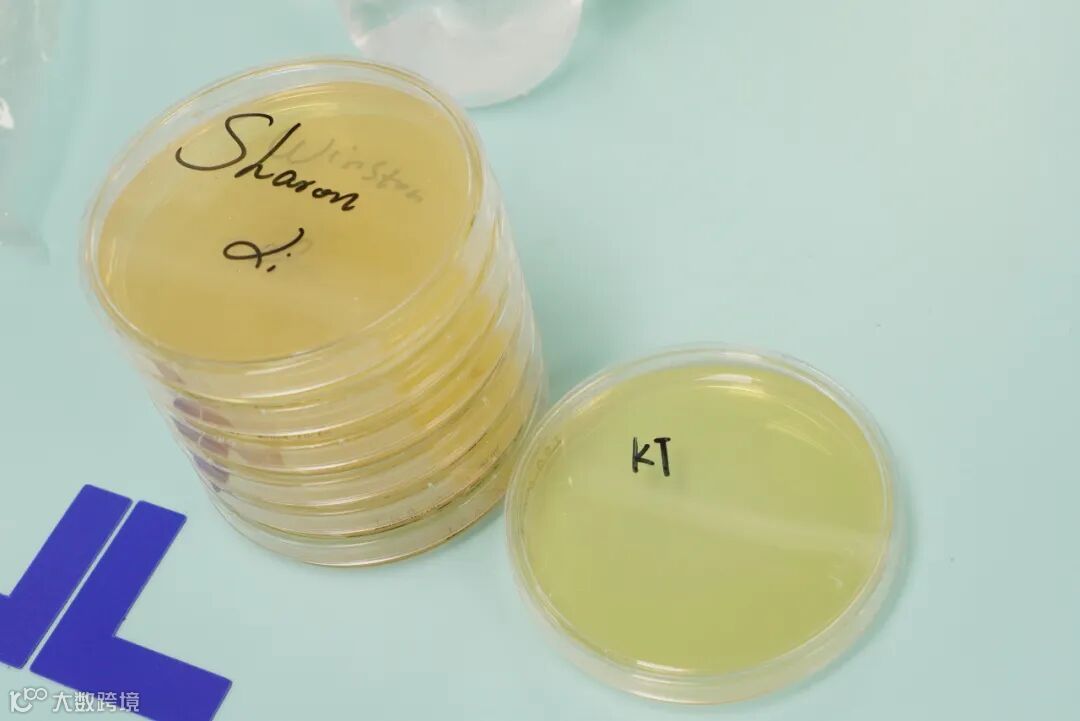
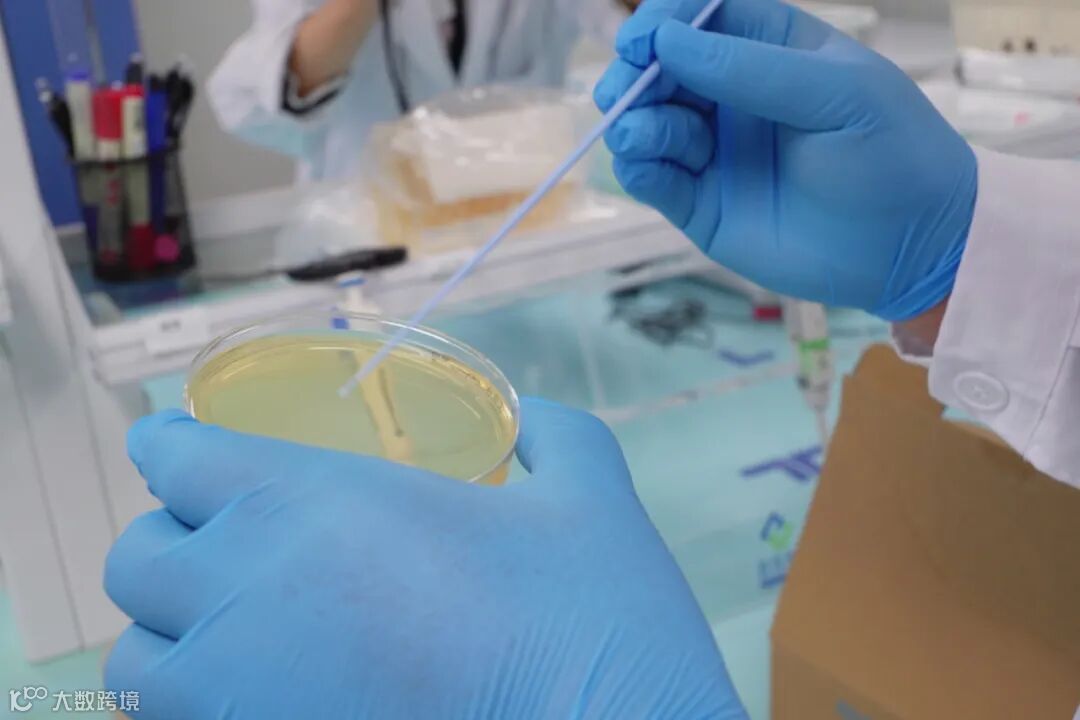

Part .01

少年的职业探索日
九年级,正值人生中一个微妙的十字路口,站在青少年与青年的门槛上,少年们开始朦胧思索“我会成为怎样的人”“我将选择怎样的人生方向”。12月24日,黄埔综合细胞库迎来了一群目光中交织着好奇与思索的少年,他们是BBSG博萃德学校九年级的学子,他们把答案的寻找之地选在了这里。在这里,他们试图寻找关于未来的答案,他们告别课本里的抽象文字,以生命科学为密钥,让学习与真实世界的脉搏紧紧相连。

Part .02
科普展厅学习交流
初入黄埔综合细胞库,科普展厅的前沿知识便为学子们打开了新世界的大门。随后,科普教育基地的系统讲解、医学检验实验室的精密仪器、干细胞GMP工厂的标准化流程、生物样本库的海量储备以及生物信息大数据中心的智能分析,一步步刷新着他们对生命科学的认知。课堂上也曾习得生物理论,但当抽象的知识点转化为眼前可触可感的科研场景,当书本上的示意图变成真实运转的实验设备,学子们才真正读懂了知识的重量与应用的价值。

Part .03
在职岗位分享
在职岗位分享环节,不同角色的从业者带来了更鲜活的职业图景。质控部负责人金晟细致拆解实验质控的每一个关键节点,让学子们明白严谨是科研的底色;技术负责人岳建辉用生动的讲述勾勒出细胞世界的神奇奥秘,点燃了大家对未知的好奇;HR负责人邓展鹏则分享了“翻译不同行业语言”的处事智慧,让他们知晓跨领域沟通的重要性。这些真诚的分享,像一束束光,穿透了成长的迷茫,让这群处于人生十字路口的少年对“职业”二字有了更具体的想象。

Part .04
实验室模拟实验
如果说理论科普勾起了探索兴趣,那么实验室模拟实验便是夯实科学种子的沃土。在导师的指导下,学子们透过倒置显微镜观察不同细胞的形态,在DNA提取实验中亲眼见证螺旋结构的真实模样。每一次操作的小心翼翼,每一次发现的惊叹欢呼,都让抽象的科学原理变得鲜活可感,也让他们在实践中体会到探索的艰辛与收获的喜悦。

Part .05
主题讲座分享收获良多
一天的沉浸式探索接近尾声,成果展示环节成为学子们梳理收获的舞台。而在他们分享感悟之前,王兵教授关于生物科技临床转化应用的详尽讲解,更补齐了大家对“科学价值”的认知拼图。从实验室到病床的转化历程,让学子们深刻理解到,生命科学的探索从来不是孤立的研究,而是与人类健康紧密相连的使命担当。
帮助学生培养个人兴趣、挖掘独特潜能、实现个性化发展,是BBSG秉持的教学理念,这与瑞因科普教育基地的追求不谋而合。这场职业探索日,不仅让学子们在生命科学的世界里找到了成长的方向,更让他们懂得了学习的意义——将知识与真实世界链接,用探索精神解决有挑战的真实问题,方能为未来的工作与生活筑牢根基。当生命的微光被解码,成长的航向便愈发清晰,这便是这场探索之旅最珍贵的馈赠。

Part .06
陈希精彩演讲现场
探索的余温未散,瑞因集团执行副总裁陈希便走进BBSG,为学子们带来深化职业思考的成长赋能演讲。她开篇打破固有认知:“大学与高中绝非世外桃源,理想世界的构建始于对现实的主动改造。”
谈及学习意义,她精准呼应此次探索:“你们所学的生物、化学、数学等知识,正是解码生命的底层代码,跨学科融合方能支撑精准医疗等前沿突破。”针对知识迭代,她也给出指引:“知识迭代无需恐慌,掌握科学思维与逻辑便可控御未来。”
演讲尾声,她以行业前辈视角叮嘱:“请常怀对自然的敬畏与对自我的惊叹,认清职业光环背后是漫长试错与孤独坚守——唯有以执行力拥抱过程、与失败为友,方能在现实磨砺中抵达理想之光。”这番话升华了职业探索的核心议题,也为迷茫中的少年送上理想与成长的珍贵指引。
END